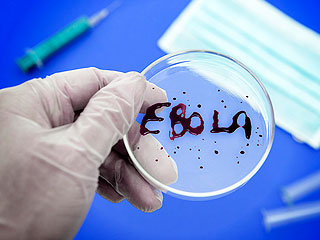
Раскрыта тайна вируса Эбола Раскрыта тайна вируса Эбола

10 октября, четверг | ![]() ![]() ![]() |
![]() | ПОЛИТИКА | ЭКОНОМИКА | ОБЩЕСТВО | ПРОИСШЕСТВИЯ | КУЛЬТУРА | СПОРТ | МЕДИА | В МИРЕ | АВТО | ТЕХНОЛОГИИ | ![]() |
| Фоторепортажи | Видеосюжеты | Комментарии | Погода | Работа | Форум | Карта | Подписка и RSS | Реклама| О газете |
Раскрыта тайна вируса Эбола15 августа 2014, пятница, 11:59 – БРЯНСК.RU | Комментарии: 0
| Версия для печати Ученым удалось раскрыть механизм действия вируса Эбола на иммунную систему человека. Это должно способствовать улучшению работы над эффективным лекарством против эпидемии.Распространение вируса Эбола заставило многих ученых-эпидемиологов пересмотреть свои взгляды на вирусные инфекции, а также заняться подробным изучением как самой болезни, так и средств борьбы с ней. Исследователи утверждают, что им удалось разгадать тайну смертельной эпидемии. Так, в ходе эволюции многие вирусы научились с разной степенью эффективности противостоять иммунитету человека. Для этого механизм болезни стал предусматривать затруднение выработки интерферонов, что тормозило работу иммунитета. Вирус Эбола обзавелся уникальной способностью дезактивации работы интерферонов, механизм которой не был изучен. Команда ученых из Медицинской школы Вашингтонского университета в Сент-Луисе, работавшая в сотрудничестве с исследователями Юго-западного медицинского центра при Университете Техаса и другими специалистами, открыла белок eVP24 (e-Ebola, VP-Virus Protein, "вирусный белок", 24 – порядковый номер в геноме). Он практически полностью блокирует реакцию иммунитета на вторжение. Так вирус получает возможность свободно размножаться в пределах организма, после чего блокировка иммунитета ему уже не нужна: последующая реакция со стороны клеток защитной системы на многократно увеличившиеся ряды вируса может быть настолько мощной, что жизненно важные органы оказываются необратимо поврежденными, передают Вести.Ru. "В рамках нашего исследования мы впервые демонстрируем, как белок вируса Эбола глушит сигналы, посылаемые интерферонами. Эти знания уже используются для разработки лекарств против лихорадки Эбола, которая пока находится на очень ранних стадиях развития", – говорит один из соавторов исследования – Кристофер Баслер из медицинского комплекса Маунт-Синай в США. Ведущий автор работы Гайя Амарасингхе из Вашингтонского университета в Сент-Луисе сообщает, что новые знания о структуре белка eVP24 и механизме его действия помогут понять природу заболевания, а в дальнейшем – победить его. Доктор Баслер полагает, что найти антитела или молекулы, блокирующие eVP24, теперь уже будет не так сложно. Главное – сейчас медики понимают, что нужно искать. Также он считает, что при лечении лихорадки Эбола может быть полезным дополнительное вливание интерферона, как это делается, к примеру, при гепатите С. Источник:
|
![]() | ПОЛИТИКА | ЭКОНОМИКА | ОБЩЕСТВО | ПРОИСШЕСТВИЯ | КУЛЬТУРА | СПОРТ | МЕДИА | В МИРЕ | АВТО | ТЕХНОЛОГИИ | ![]() |
| Фоторепортажи | Видеосюжеты | Комментарии | Погода | Работа | Форум | Карта | Подписка и RSS | Реклама| О газете |
| Размещение рекламы в газете БРЯНСК.RU: Прайс-лист, тел. (4832) 37-19-38, почта info@briansk.ru Для информационных писем в редакцию: news@briansk.ru | ![]() | ![]() | ||
| 2005–2015 © Ежедневная интернет-газета БРЯНСК.RU При цитировании активная ссылка на БРЯНСК.RU обязательна Материалы газеты могут содержать информацию 18+ | ![]() | Открыв данный сайт, Вы соглашаетесь с Правилами cайта (договор-оферта). Если вы не согласны с Правилами, немедленно покиньте сайт! | ![]() |

В глубине экрана: Мастер-класс по ремонту телевизоров
Погружение в мир футбола онлайн: для поклонников Игры
Займ без проверок
Тотализаторы: что это такое и чем они отличаются от обычных ставок?
Играть в бесплатные игровые автоматы в онлайн-клубе Вулкан
Стоит ли посещать офтальмолога при замене очков?
Успешные игроки предпочитают игровые автоматы Вулкан
Новое казино Супер Слотс поможет воплотить ваши мечты в реальность







ПОПУЛЯРНЫЕ МАТЕРИАЛЫ










